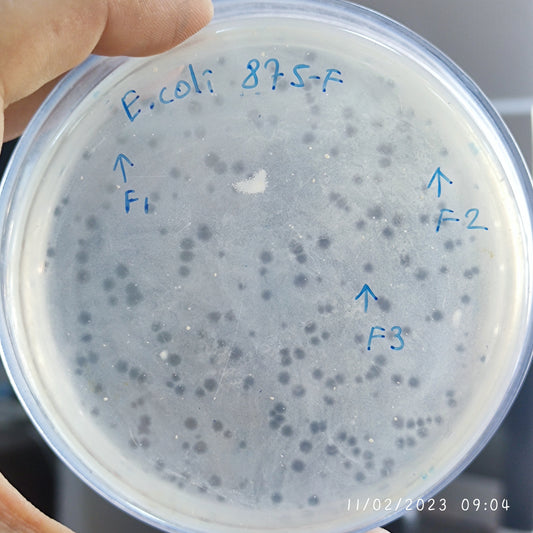
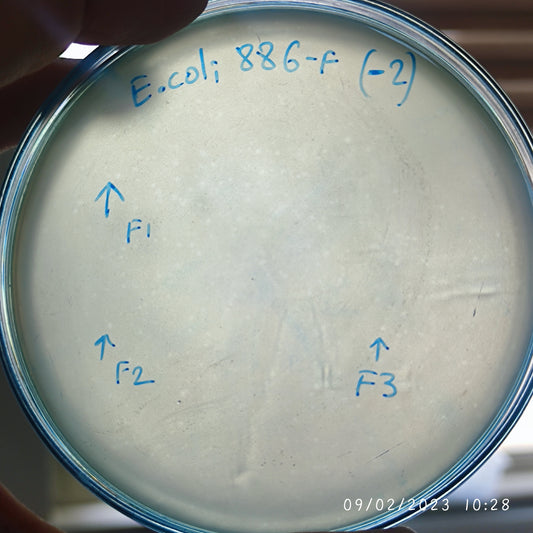
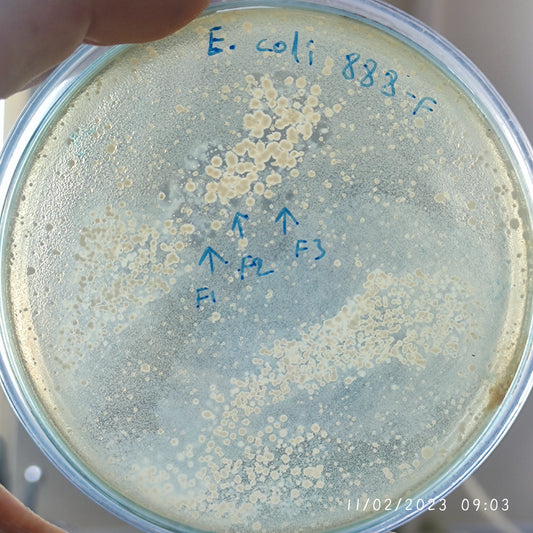
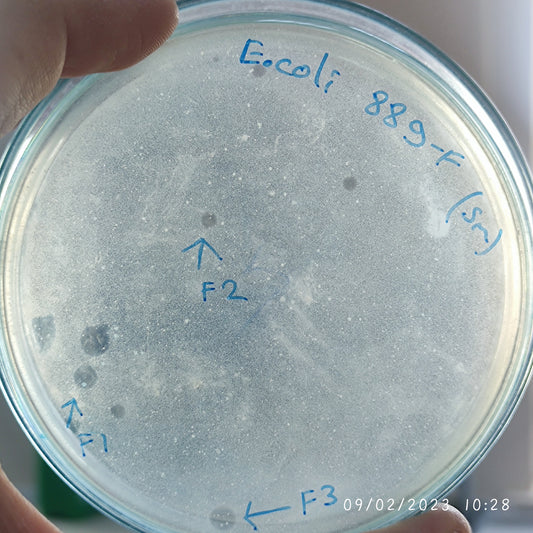
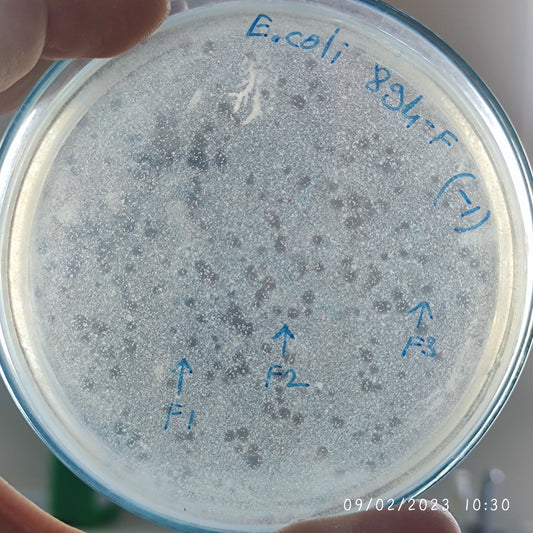
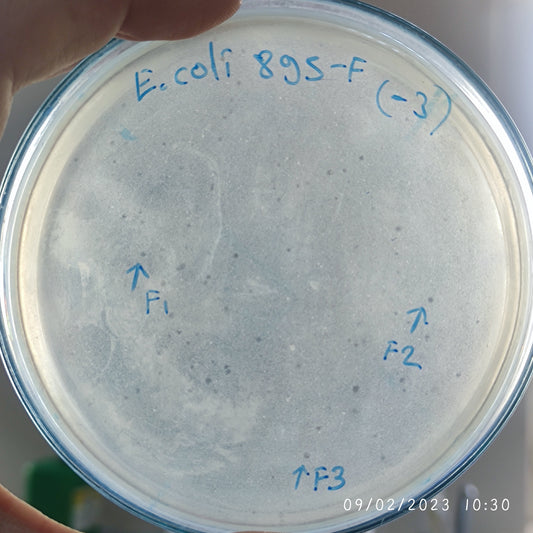
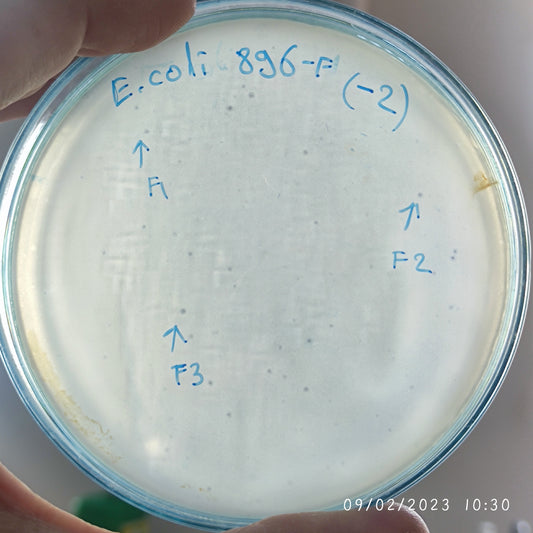
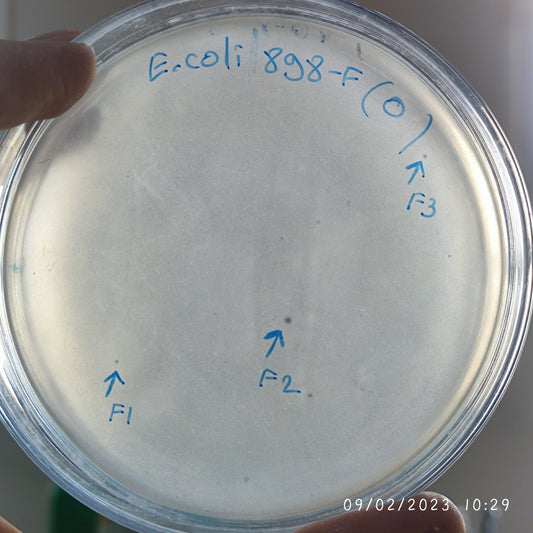
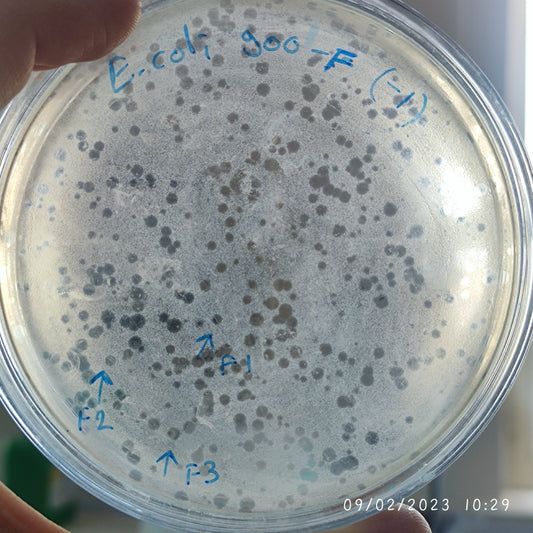
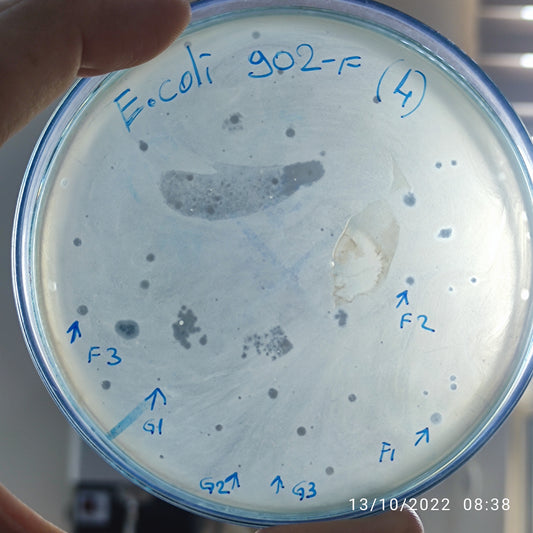

-
Escherichia coli bacteriophage 100875F
Regular price $750.00 USDRegular priceUnit price per -
Escherichia coli bacteriophage 100877F
Regular price $750.00 USDRegular priceUnit price per -
Escherichia coli bacteriophage 100879F
Regular price $800.00 USDRegular priceUnit price per -
Escherichia coli bacteriophage 100882F
Regular price $800.00 USDRegular priceUnit price per -
Escherichia coli bacteriophage 100886F
Regular price $650.00 USDRegular priceUnit price per -
Escherichia coli bacteriophage 100888F
Regular price $700.00 USDRegular priceUnit price per -
Escherichia coli bacteriophage 100889F
Regular price $800.00 USDRegular priceUnit price per -
Escherichia coli bacteriophage 100893F
Regular price $750.00 USDRegular priceUnit price per -
Escherichia coli bacteriophage 100894F
Regular price $750.00 USDRegular priceUnit price per -
Escherichia coli bacteriophage 100895F
Regular price $800.00 USDRegular priceUnit price per -
Escherichia coli bacteriophage 100896F
Regular price $700.00 USDRegular priceUnit price per -
Escherichia coli bacteriophage 100897F
Regular price $800.00 USDRegular priceUnit price per -
Escherichia coli bacteriophage 100898F
Regular price $750.00 USDRegular priceUnit price per -
Escherichia coli bacteriophage 100900F
Regular price $900.00 USDRegular priceUnit price per -
Escherichia coli bacteriophage 100901F
Regular price $500.00 USDRegular priceUnit price per -
Escherichia coli bacteriophage 100902F
Regular price $500.00 USDRegular priceUnit price per